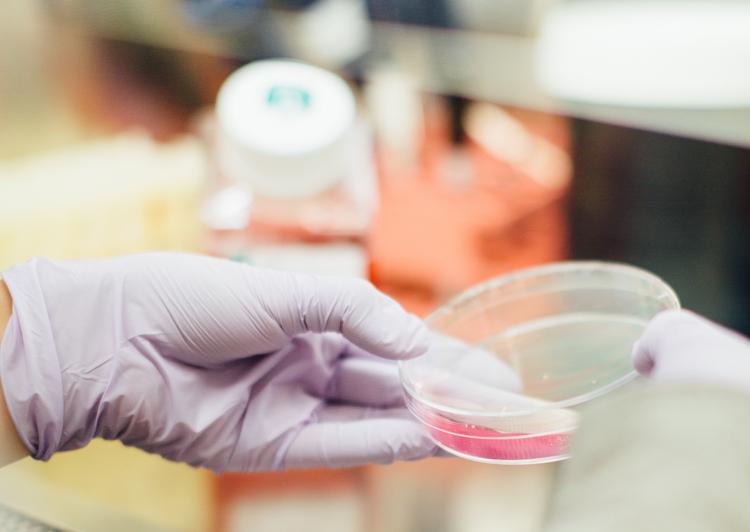
gel hydroalcoolique bactérie résistante hôpital Melbourne Australie étude scientifique Etats-Unis

Après quasiment 20 années de controverse, les autorités australiennes ont accepté mercredi d'abolir une taxe "tampon" sur certains produits d'hygiène féminine jugée sexiste.
Lorsque Canberra avait instauré en 2000 une TVA de 10%, les produits d'hygiène jugés bénéfiques pour la santé tels que les préservatifs ou les crèmes solaires en avaient été exonérés, à l'instar de la plupart des denrées alimentaires.
Mais, en dépit des récriminations, les tampons et d'autres produits d'hygiène féminins y furent soumis.
Dénoncée comme étant "sexiste" par les défenseurs des droits des femmes, la taxe est depuis une source de querelles incessantes entre Canberra d'une part, et les gouvernements des États et Territoires d'autre part, lesquels profitent des recettes créées par l'impôt.
En 2000, le ministre de la Santé Michael Wooldridge s'était illustré en expliquant que les tampons ne devaient pas être exemptés de TVA au motif qu'ils "ne préviennent pas les maladie".
"En tant qu’homme, j'aimerais que la crème à raser soit exemptée mais je ne m'attends pas à ce que ça arrive", avait-il expliqué à la télévision publique ABC, suscitant un tollé.
Des campagnes intitulées "Arrêtez de taxer mes règles!" avaient été lancées et des groupes de militantes comme "les vengeresses de la menstruation" avaient été créés.
Les partisans de l'exemption se retrouvaient des deux côtés de l'échiquier politique fédéral, d'autres évitaient soigneusement le sujet, renvoyant la patate chaude aux autorités des États et Territoires.
Les ministres des Finances des États et Territoires ont cependant décidé à l'unanimité mercredi d'abolir la taxe à compter de janvier, acceptant de renoncer à environ 30 millions de dollars australiens de recettes fiscales annuelles (18,5 millions d'euros).
"L'histoire (de la taxe) est longue et tortueuse", a déclaré la ministre fédérale des Femmes Kelly O'Dwyer. "Je suis heureuse d'annoncer que nous avons réussi, les États et Territoires nous ont rejoint et des millions d'Australiennes vont en bénéficier".
La coalition conservatrice au pouvoir à Canberra cherche à conquérir l'électorat féminin après une série de plaintes de parlementaires qui ont dénoncé le harcèlement dans ses rangs.
En août, lors d'un putsch au sein du parti au pouvoir qui avait débouché sur le limogeage du Premier ministre modéré Malcolm Turnbull, la ministre des Affaires étrangères Julie Bishop avait été une victime collatérale, illustrant la misogynie de sa formation politique.
Sur le même sujet